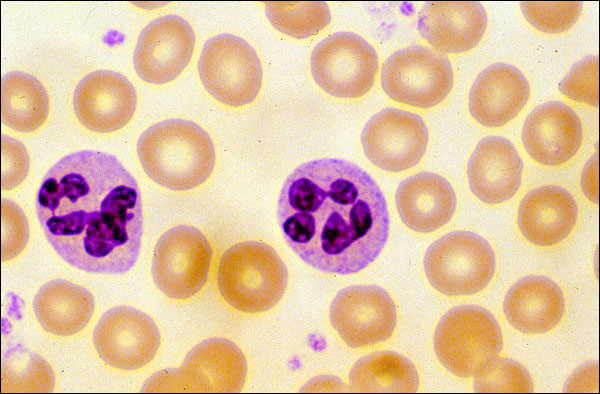

Neutrophil
Click picture to enlarge. Close window to return
This is the most common polymorphonuclear leukocyte (the other two being the basophil and the eosinophil). The name stems from the relatively neutral color that its granules have when routinely stained. The neutrophil arises from the bone marrow and is fully mature when it is released into the circulation. It is, therefore, fully prepared to function in its role as the first line of cellular defense. It becomes activated, i.e., augmented in its ability to perform many of its functions, by exposing it to certain proinflammatory mediators and the chemotactic factors that attract it to the site of an inciting stimulus. It it voraciously phagocytic -- to the extent that it, along with the macrophage -- has been termed a "professional" phagocyte, thereby distinguishing them from other cell types that are capable of ingesting things, but not to the same extent